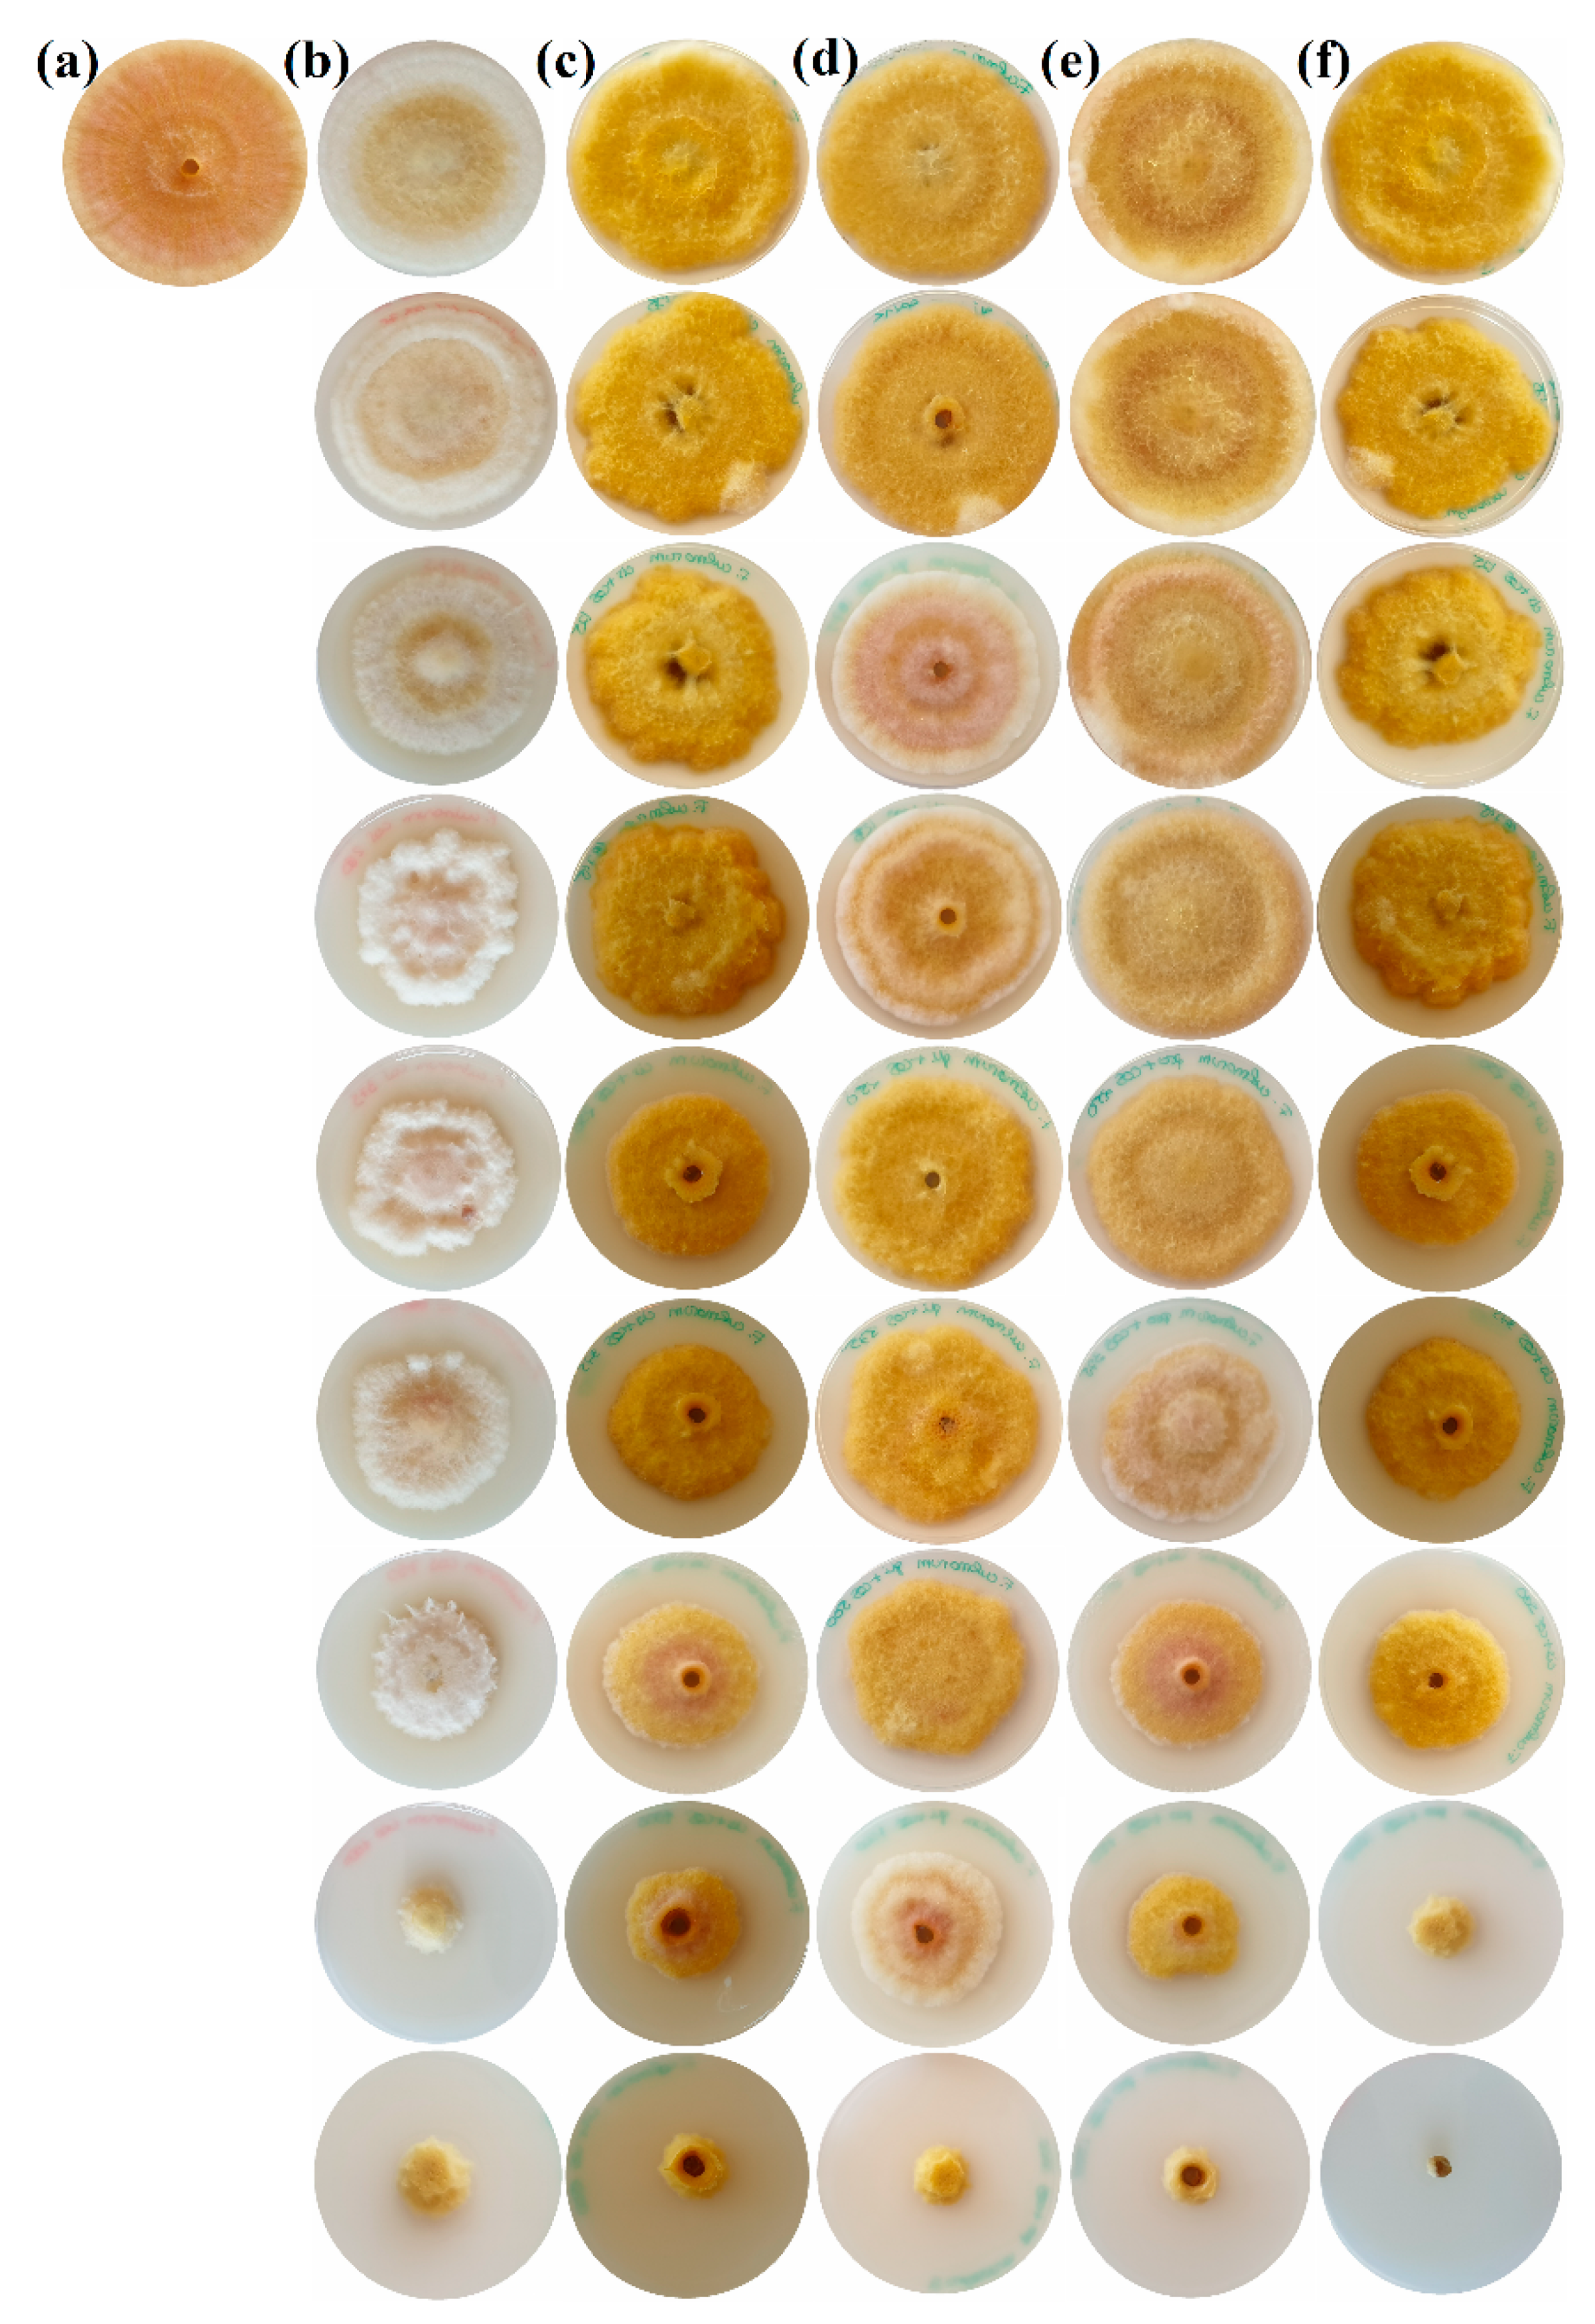
Agronomy 10 01427 g002 Agronomy 10 01427 g002
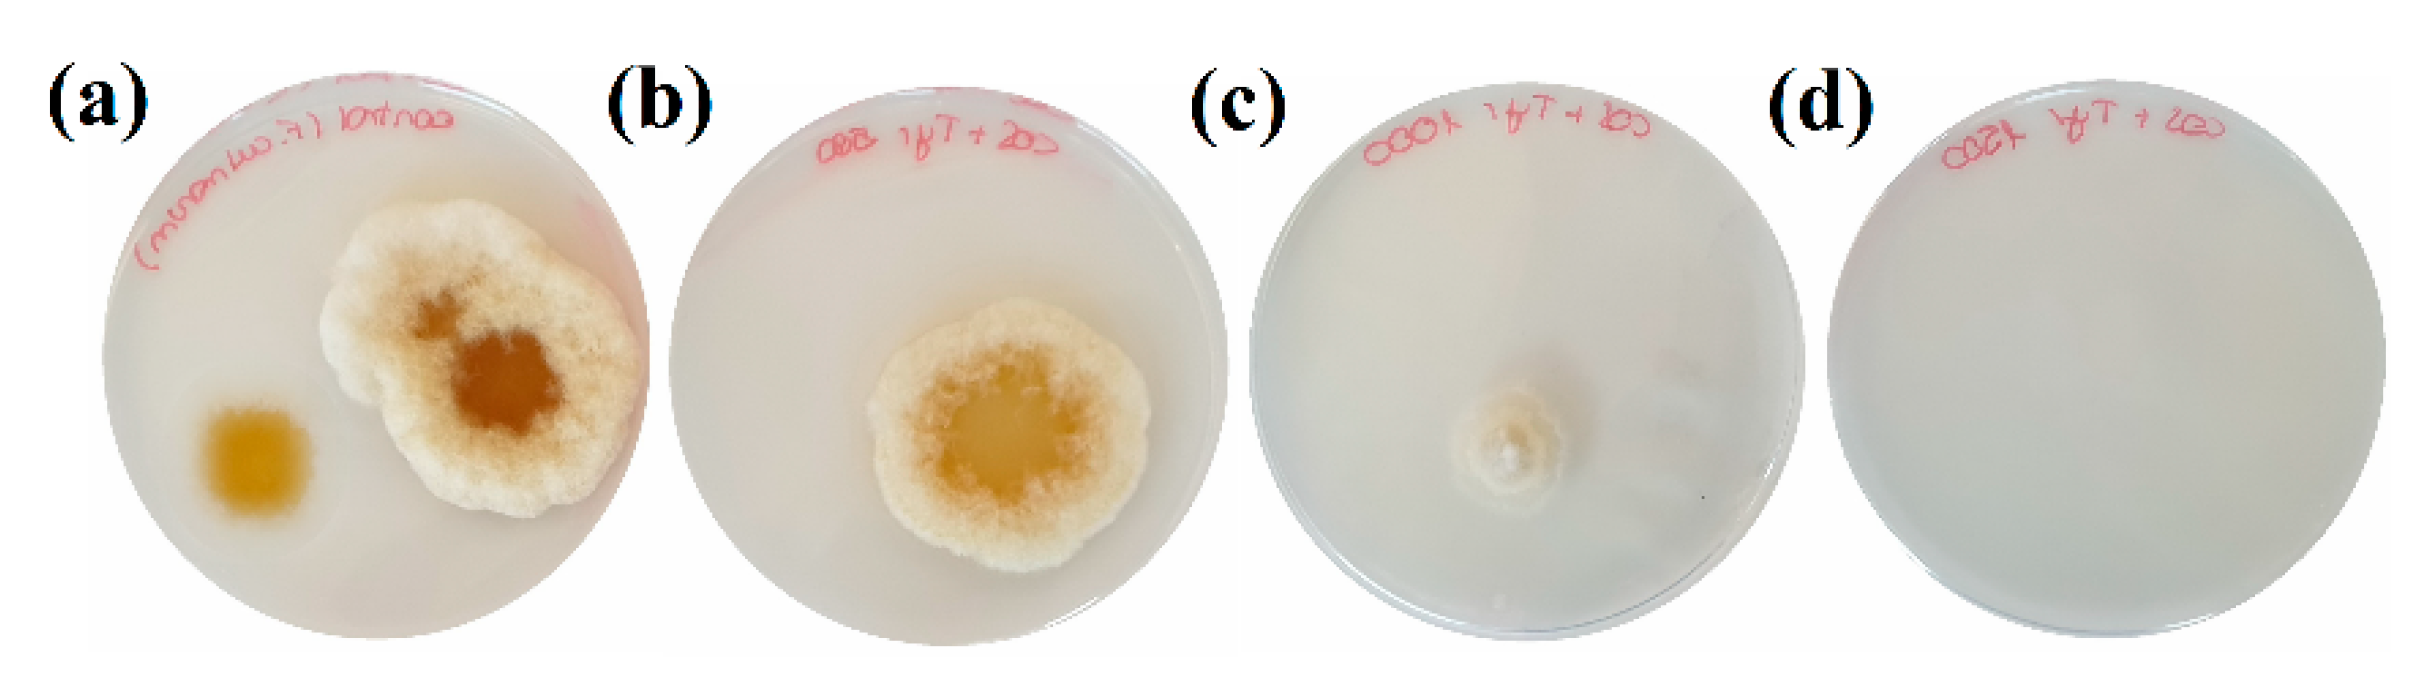
Agronomy 10 01427 g003 Agronomy 10 01427 g003

Antifungal Activity of Chitosan Oligomers–Amino Acid Conjugate Complexes against Fusarium culmorum in Spelt (Triticum spelta L.)
Abstract
1. Introduction
2. Materials and Methods
2.1. Reagents and Fungal Isolates
2.2. Preparation of Chitosan Oligomers and Bioactive Solutions
2.3. In Vitro Tests of Mycelial Growth Inhibition
2.4. Preparation of Inoculum
2.5. Inhibition of Colonies Formation
2.6. Effect of Conjugate Complexes on Mycotoxin Production and Mycotoxin Chemical Analysis
2.7. In Vitro Seedling Tests
2.8. Field Trials
2.9. Statistical Analyses
3. Results
3.1. In Vitro Tests of Mycelial Growth Inhibition
3.2. Inhibition of Colonies Formation
3.3. Effect on Mycotoxin Production
3.4. Seedling Tests
3.5. Field Trials
4. Discussion
4.1. Comparison of Treatment Efficacy
4.2. Mechanism of Action
4.3. Significance of the Reported Findings
4.4. Limitations of the Study and Further Research
5. Conclusions
6. Patents
Author Contributions
Funding
Acknowledgments
Conflicts of Interest
References
- Figueroa, M.; Hammond-Kosack, K.E.; Solomon, P.S. A review of wheat diseases-a field perspective. Mol. Plant Pathol. 2017, 19, 1523–1536. [Google Scholar] [CrossRef] [PubMed]
- Mishra, S.; Srivastava, S.; Dewangan, J.; Divakar, A.; Rath, S.K. Global occurrence of deoxynivalenol in food commodities and exposure risk assessment in humans in the last decade: A survey. Crit. Rev. Food Sci. Nutr. 2019, 60, 1346–1374. [Google Scholar] [CrossRef] [PubMed]
- Khaneghah, A.M.; Martins, L.M.; Von Hertwig, A.M.; Bertoldo, R.; Sant’Ana, A.S. Deoxynivalenol and its masked forms: Characteristics, incidence, control and fate during wheat and wheat based products processing - A review. Trends Food Sci. Technol. 2018, 71, 13–24. [Google Scholar] [CrossRef]
- Leslie, J.F.; Summerell, B.A. The Fusarium Laboratory Manual, 1st ed.; Blackwell Publishing: Ames, IA, USA, 2006; p. 388. [Google Scholar]
- Valverde-Bogantes, E.; Bianchini, A.; Herr, J.R.; Rose, D.J.; Wegulo, S.N.; Hallen-Adams, H.E. Recent population changes of Fusarium head blight pathogens: Drivers and implications. Can. J. Plant Pathol. 2019, 1–15. [Google Scholar] [CrossRef]
- Llorens, A.; Hinojo, M.J.; Mateo, R.; Medina, A.; Valle-Algarra, F.M.; González-Jaén, M.T.; Jiménez, M. Variability and characterization of mycotoxin-producing Fusarium spp isolates by PCR-RFLP analysis of the IGS-rDNA region. Antonie van Leeuwenhoek 2006, 89, 465–478. [Google Scholar] [CrossRef]
- Quarta, A.; Mita, G.; Haidukowski, M.; Santino, A.; Mulè, G.; Visconti, A. Assessment of trichothecene chemotypes of Fusarium culmorum occurring in Europe. Food Addit. Contam. 2005, 22, 309–315. [Google Scholar] [CrossRef]
- Foroud, N.A.; Baines, D.; Gagkaeva, T.Y.; Thakor, N.; Badea, A.; Steiner, B.; Bürstmayr, M.; Bürstmayr, H. Trichothecenes in cereal grains—An update. Toxins 2019, 11, 634. [Google Scholar] [CrossRef]
- Tini, F.; Beccari, G.; Onofri, A.; Ciavatta, E.; Gardiner, D.M.; Covarelli, L. Fungicides may have differential efficacies towards the main causal agents of Fusarium head blight of wheat. Pest Manag. Sci. 2020. [Google Scholar] [CrossRef]
- Kim, S.H.; Vujanovic, V. Relationship between mycoparasites lifestyles and biocontrol behaviors against Fusarium spp. and mycotoxins production. Appl. Microbiol. Biotechnol. 2016, 100, 5257–5272. [Google Scholar] [CrossRef]
- Yan, Z.; Zhang, H.; Van Der Lee, T.; Waalwijk, C.; Van Diepeningen, A.; Deng, Y.; Feng, J.; Liu, T.; Chen, W. Resistance to Fusarium head blight and mycotoxin accumulation among 129 wheat cultivars from different ecological regions in China. World Mycotoxin J. 2020, 13, 189–200. [Google Scholar] [CrossRef]
- Gebremariam, E.S.; Karakaya, A.; Erginbas-Orakci, G.; A Dababat, A.; Paulitz, T.C. Assessment of the Seedling Resistance of Spring Wheat Lines to Fusarium culmorum. Tarım Bilim. Derg. 2020. [Google Scholar] [CrossRef]
- Kadžienė, G.; Suproniene, S.; Auskalniene, O.; Pranaitiene, S.; Svegzda, P.; Versuliene, A.; Ceseviciene, J.; Janusauskaite, D.; Feiza, V. Tillage and cover crop influence on weed pressure and Fusarium infection in spring cereals. Crop. Prot. 2020, 127, 104966. [Google Scholar] [CrossRef]
- Shaposhnikov, A.I.; Shakhnazarova, V.Y.; Vishnevskaya, N.A.; Borodina, E.V.; Strunnikova, O. Aromatic Carboxylic Acids in Barley-Root Exudates and Their Influence on the Growth of Fusarium culmorum and Pseudomonas fluorescens. Appl. Biochem. Microbiol. 2020, 56, 344–351. [Google Scholar] [CrossRef]
- Krzyśko-Łupicka, T.; Sokół, S.; Piekarska-Stachowiak, A.A. Evaluation of Fungistatic Activity of Eight Selected Essential Oils on Four Heterogeneous Fusarium Isolates Obtained from Cereal Grains in Southern Poland. Molecules 2020, 25, 292. [Google Scholar] [CrossRef]
- Behiry, S.I.; Nasser, R.A.; El-Kareem, M.S.A.; Ali, H.M.; Salem, M.Z.M. Mass Spectroscopic Analysis, MNDO Quantum Chemical Studies and Antifungal Activity of Essential and Recovered Oil Constituents of Lemon-Scented Gum against Three Common Molds. Processes 2020, 8, 275. [Google Scholar] [CrossRef]
- Zefzoufi, M.; Smaili, A.; Fdil, R.; Rifai, L.A.; Faize, L.; Koussa, T.; Makroum, K.; Ben Ali, A.; Tabyaoui, M.; Mouzdahir, A.; et al. Composition of essential oil of Moroccan Dysphania ambrosioides and its antimicrobial activity against bacterial and fungal phytopathogens. J. Plant Pathol. 2019, 102, 47–58. [Google Scholar] [CrossRef]
- Wianowska, D.; Garbaczewska, S.; Cieniecka-Roslonkiewicz, A.; Dawidowicz, A.L.; Typek, R.; Kielczewska, A. Influence of the Extraction Conditions on the Antifungal Properties of Walnut Green Husk Isolates. Anal. Lett. 2020, 53, 1970–1981. [Google Scholar] [CrossRef]
- Keriene, I.; Mankeviciene, A.; Blazyte, J. The effect of antifungal extracts on the contamination of grain with microfungi. Food Sci. Nutr. 2020, 8, 1375–1382. [Google Scholar] [CrossRef]
- Matei, P.M.; Iacomi, B.; Martín-Gil, J.; Pérez-Lebeña, E.; Ramos-Sánchez, M.D.C.; Barrio-Arredondo, M.T.; Martín-Ramos, P. In Vitro Antifungal Activity of Composites of AgNPs and Polyphenol Inclusion Compounds against Fusarium culmorum in Different Dispersion Media. Agronomy 2018, 8, 239. [Google Scholar] [CrossRef]
- Buzón-Durán, L.; Martín-Gil, J.; Ramos-Sánchez, M.D.C.; Pérez-Lebeña, E.; Marcos-Robles, J.L.; Fombellida-Villafruela, Á.; Martín-Ramos, P. Antifungal Activity against Fusarium culmorum of Stevioside, Silybum marianum Seed Extracts, and Their Conjugate Complexes. Antibiotics 2020, 9, 440. [Google Scholar] [CrossRef]
- Bell, A.A.; Hubbard, J.C.; Liu, L.; Davis, R.M.; Subbarao, K.V. Effects of Chitin and Chitosan on the Incidence and Severity of Fusarium Yellows of Celery. Plant Dis. 1998, 82, 322–328. [Google Scholar] [CrossRef] [PubMed]
- Park, R.-D.; Jo, K.-J.; Jo, Y.-Y.; Jin, Y.-L.; Kim, K.-Y.; Shim, J.-H.; Kim, Y.-W. Variation of antifungal activities of chitosans on plant pathogens. J. Microbiol. Biotechnol. 2002, 12, 84–88. [Google Scholar]
- Al-Hetar, M.Y.; Abidin, M.A.Z.; Sariah, M.; Wong, M.Y. Antifungal activity of chitosan against Fusarium oxysporum f. sp. cubense. J. Appl. Polym. Sci. 2010, 120, 2434–2439. [Google Scholar] [CrossRef]
- Xing, K.; Shen, X.; Zhu, X.; Ju, X.; Miao, X.; Tian, J.; Feng, Z.; Peng, X.; Jiang, J.; Qin, S. Synthesis and in vitro antifungal efficacy of oleoyl-chitosan nanoparticles against plant pathogenic fungi. Int. J. Boil. Macromol. 2016, 82, 830–836. [Google Scholar] [CrossRef] [PubMed]
- Maluin, F.N.; Hussein, M. Chitosan-Based Agronanochemicals as a Sustainable Alternative in Crop Protection. Molecules 2020, 25, 1611. [Google Scholar] [CrossRef]
- Buzón-Durán, L.; Martín-Gil, J.; Pérez-Lebeña, E.; Ruano-Rosa, D.; Revuelta, J.L.; Gascón, J.C.; Ramos-Sánchez, M.D.C.; Martín-Ramos, P. Antifungal Agents Based on Chitosan Oligomers, ε-polylysine and Streptomyces spp. Secondary Metabolites against Three Botryosphaeriaceae Species. Antibiotics 2019, 8, 99. [Google Scholar] [CrossRef]
- Balouiri, M.; Sadiki, M.; Ibnsouda, S.K. Methods for in vitro evaluating antimicrobial activity: A review. J. Pharm. Anal. 2016, 6, 71–79. [Google Scholar] [CrossRef]
- Khan, M.R.; Doohan, F. Comparison of the efficacy of chitosan with that of a fluorescent pseudomonad for the control of Fusarium head blight disease of cereals and associated mycotoxin contamination of grain. Boil. Control. 2009, 48, 48–54. [Google Scholar] [CrossRef]
- Kheiri, A.; Jorf, S.A.M.; Malihipour, A.; Saremi, H.; Nikkhah, M. Application of chitosan and chitosan nanoparticles for the control of Fusarium head blight of wheat ( Fusarium graminearum ) in vitro and greenhouse. Int. J. Boil. Macromol. 2016, 93, 1261–1272. [Google Scholar] [CrossRef]
- Perczak, A.; Gwiazdowska, D.; Marchwińska, K.; Juś, K.; Gwiazdowski, R.; Waśkiewicz, A. Antifungal activity of selected essential oils against Fusarium culmorum and F. graminearum and their secondary metabolites in wheat seeds. Arch. Microbiol. 2019, 201, 1085–1097. [Google Scholar] [CrossRef]
- Jeyakumar, J.M.J.; Zhang, M.; Thiruvengadam, M. Determination of mycotoxins by HPLC, LC-ESI-MS/MS, and MALDI-TOF MS in Fusarium species-infected sugarcane. Microb. Pathog. 2018, 123, 98–110. [Google Scholar] [CrossRef] [PubMed]
- Orzali, L.; Forni, C.; Riccioni, L. Effect of chitosan seed treatment as elicitor of resistance to Fusarium graminearum in wheat. Seed Sci. Technol. 2014, 42, 132–149. [Google Scholar] [CrossRef]
- International Rules for Seed Testing; International Seed Testing Association: Bassersdorf, Switzerland, 2020; Volume 2020, p. i-19-18. [CrossRef]
- Lozano-Ramírez, N.; Mezzalama, M.; Carballo-Carballo, A.; Hernández-Livera, A. Efectos de fungicidas en la calidad fisiológica de la semilla de trigo harinero (Triticum aestivum L.) y su eficacia en el control de Fusarium graminearum Schwabe [Gibberella zeae (Schwein.) Petch.] y Bipolaris sorokiniana (Sacc.) Shoemaker [Cochliobolus sativus S. Ito y Kurib.]. Revi. Mex. Fitopatol. 2006, 24, 115–121. [Google Scholar]
- Koch, E.; Weil, B.; Wachter, R.; Wohlleben, S.; Spiess, H.; Krauthausen, H.-J. Evaluation of selected microbial strains and commercial alternative products as seed treatments for the control of Tilletia tritici, Fusarium culmorum, Drechslera graminea and D. teres. J. Plant Dis. Prot. 2006, 113, 150–158. [Google Scholar] [CrossRef]
- Schillinger, W.F.; Cook, R.J.; Papendick, R.I. Increased Dryland Cropping Intensity with No-Till Barley. Agron. J. 1999, 91, 744–752. [Google Scholar] [CrossRef]
- Brennan, J.M.; Egan, D.; Cooke, B.M.; Doohan, F. Effect of temperature on head blight of wheat caused by Fusarium culmorum and F. graminearum. Plant Pathol. 2005, 54, 156–160. [Google Scholar] [CrossRef]
- Parry, D.W.; Bayles, R.A.; Priestley, R.H. Resistance of winter wheat varieties to ear blight (Fusarium culmorum). J. Nat. Inst. Agric. Bot. 1984, 16, 65–468. [Google Scholar]
- Al-Hatmi, A.M.S.; Curfs-Breuker, I.; De Hoog, S.; Meis, J.F.; E Verweij, P. Antifungal Susceptibility Testing of Fusarium: A Practical Approach. J. Fungi 2017, 3, 19. [Google Scholar] [CrossRef]
- Khan, M.; Fischer, S.; Egan, D.; Doohan, F. Biological Control of Fusarium Seedling Blight Disease of Wheat and Barley. Phytopathol. 2006, 96, 386–394. [Google Scholar] [CrossRef]
- Wiwart, M.; Suchowilska, E.; Kandler, W.; Sulyok, M.; Wachowska, U.; Krska, R. The Response of Selected Triticum spp. Genotypes with Different Ploidy Levels to Head Blight Caused by Fusarium culmorum (W.G.Smith) Sacc. Toxins 2016, 8, 112. [Google Scholar] [CrossRef]
- Ing, L.Y.; Zin, N.M.; Sarwar, A.; Katas, H. Antifungal Activity of Chitosan Nanoparticles and Correlation with Their Physical Properties. Int. J. Biomater. 2012, 2012, 1–9. [Google Scholar] [CrossRef] [PubMed]
- Takara, E.A.; Vega-Hissi, E.G.; Garro-Martinez, J.C.; Marchese, J.; Ochoa, A. About endothermic sorption of tyrosine on chitosan films. Carbohydr. Polym. 2019, 206, 57–64. [Google Scholar] [CrossRef] [PubMed]
- Palma-Guerrero, J.; Lopez-Jimenez, J.A.; Pérez-Berná, A.J.; Huang, I.-C.; Jansson, H.-B.; Salinas, J.; Villalaín, J.; Read, N.D.; Lopez-Llorca, L.V. Membrane fluidity determines sensitivity of filamentous fungi to chitosan. Mol. Microbiol. 2010, 75, 1021–1032. [Google Scholar] [CrossRef]
- Farag, R.S.; Osman, S.A.; Hallabo, S.A.S.; Nasr, A.A. Linoleic Acid Oxidation Catalysed by Various Amino Acids and Cupric Ions in Aqueous Media. Fette, Seifen, Anstrichm. 1980, 82, 390–394. [Google Scholar] [CrossRef]
- Brodhun, F.; Feussner, I. Oxylipins in fungi. FEBS J. 2011, 278, 1047–1063. [Google Scholar] [CrossRef]
- Scherm, B.; Balmas, V.; Spanu, F.; Pani, G.; Delogu, G.; Pasquali, M.; Migheli, Q. Fusarium culmorum: Causal agent of foot and root rot and head blight on wheat. Mol. Plant Pathol. 2012, 14, 323–341. [Google Scholar] [CrossRef]
- El Jarroudi, M.; Kouadio, L.; Tychon, B.; El Jarroudi, M.; Junk, J.; Bock, C.H.; Delfosse, P. Modeling the Main Fungal Diseases of Winter Wheat: Constraints and Possible Solutions. In Advances in Plant Pathology; IntechOpen: London, UK, 2018; pp. 3–30. [Google Scholar]
- Pirgozliev, S.R.; Ray, R.V.; Edwards, S.; Hare, M.C.; Jenkinson, P. Effect of timing of fungicide application on the development of Fusarium head blight and the accumulation of deoxynivalenol (DON) in winter wheat grain. Cereal Res. Commun. 2008, 36, 289–299. [Google Scholar] [CrossRef]
- Pirgozliev, S.; Edwards, S.; Hare, M.; Jenkinson, P. Effect of Dose Rate of Azoxystrobin and Metconazole on the Development of Fusarium Head Blight and the Accumulation of Deoxynivalenol (DON) in Wheat Grain. Eur. J. Plant Pathol. 2002, 108, 469–478. [Google Scholar] [CrossRef]

| Concentration (µg·mL−1) | COS | Cys | Gly | Pro | Tyr | COS–Cys | COS–Gly | COS–Pro | COS–Tyr |
|---|---|---|---|---|---|---|---|---|---|
| EC50 | 680.27 | 1516.7 | - | 726.7 | 3524.8 | 820.45 | 948.39 | 675.69 | 320.46 |
| EC90 | 2230.26 | 8150.2 | - | 3460.3 | 79,197.5 | 1406.87 | 1359.08 | 1372.58 | 1106.87 |
© 2020 by the authors. Licensee MDPI, Basel, Switzerland. This article is an open access article distributed under the terms and conditions of the Creative Commons Attribution (CC BY) license (http://creativecommons.org/licenses/by/4.0/).
Share and Cite
Buzón-Durán, L.; Martín-Gil, J.; Marcos-Robles, J.L.; Fombellida-Villafruela, Á.; Pérez-Lebeña, E.; Martín-Ramos, P. Antifungal Activity of Chitosan Oligomers–Amino Acid Conjugate Complexes against Fusarium culmorum in Spelt (Triticum spelta L.). Agronomy 2020, 10, 1427. https://doi.org/10.3390/agronomy10091427
Buzón-Durán L, Martín-Gil J, Marcos-Robles JL, Fombellida-Villafruela Á, Pérez-Lebeña E, Martín-Ramos P. Antifungal Activity of Chitosan Oligomers–Amino Acid Conjugate Complexes against Fusarium culmorum in Spelt (Triticum spelta L.). Agronomy. 2020; 10(9):1427. https://doi.org/10.3390/agronomy10091427
Chicago/Turabian StyleBuzón-Durán, Laura, Jesús Martín-Gil, José Luis Marcos-Robles, Ángel Fombellida-Villafruela, Eduardo Pérez-Lebeña, and Pablo Martín-Ramos. 2020. "Antifungal Activity of Chitosan Oligomers–Amino Acid Conjugate Complexes against Fusarium culmorum in Spelt (Triticum spelta L.)" Agronomy 10, no. 9: 1427. https://doi.org/10.3390/agronomy10091427
APA StyleBuzón-Durán, L., Martín-Gil, J., Marcos-Robles, J. L., Fombellida-Villafruela, Á., Pérez-Lebeña, E., & Martín-Ramos, P. (2020). Antifungal Activity of Chitosan Oligomers–Amino Acid Conjugate Complexes against Fusarium culmorum in Spelt (Triticum spelta L.). Agronomy, 10(9), 1427. https://doi.org/10.3390/agronomy10091427

